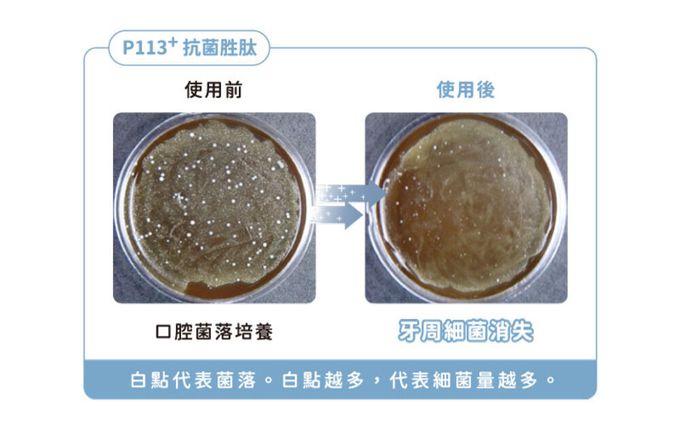

首載 App 現領 $ 100 折價券
 ( 10000+ )
( 10000+ )
1/6
折價券
可使用折價券
商品特色
全球獨家專利P113+抗菌胜肽
無添加酒精、防腐劑、三氯沙、氯己定
食品級配方 水果風味
輕巧好攜帶 隨時守護寶貝口腔
人氣卡通聯名 身受寶貝們喜歡

口碑嚴選

正品保證

加密付款

7天鑑賞
付款
信用卡・LINE Pay・街口支付・先享後付・ATM
配送
宅配
免運
介紹

看更多



